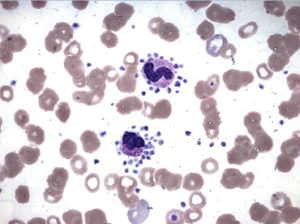
Причины пониженных нейтрофилов у детей и лечение отклонений

Получив на руки анализ крови ребенка, мамы нередко пытаются расшифровать указанные в нем цифры, не дожидаясь приема врача. Что может означать количество нейтрофилов, которое указано в бланке?
Может ли их пониженный уровень свидетельствовать об опасности для здоровья малыша и нужно ли беспокоиться по этому поводу?
В статье вы узнаете почему нейтрофилы понижены у ребенка в крови и о чем это говорит, а также про сегментоядерные и палочкоядерные нейтрофилы.
Нейтрофилы – что это такое
За защиту организма от инфекций отвечают лейкоциты – белые кровяные тельца. Их условно разделяют на агранулоциты (моноциты, лимфоциты) и гранулоциты. В последнюю группу входят клетки, имеющие зернистую структуру: базофилы, эозинофилы, нейтрофилы.
Именно нейтрофилы составляют наиболее многочисленный вид в общем числе лейкоцитарных клеток – их объем может достигать 70% у взрослых и 60% у детей. Количество меняется с возрастом.
В зависимости от формы различают такие подвиды нейтрофилов:
- Сегментоядерные, ядро которых делится на 3-5 частей перетяжками,
- Палочкоядерные, их ядро напоминает вытянутую сферу.
Более молодые клетки – палочкоядерные, они попадают в кровь и через небольшой промежуток времени превращаются в сегментоядерные.
Пониженные нейтрофилы у детей могут быть вызваны различными факторами, и врачи подчеркивают важность их своевременной диагностики. Одной из основных причин является вирусная инфекция, которая может временно снижать уровень нейтрофилов. Также к этому состоянию могут приводить аутоиммунные заболевания, недостаток витаминов и минералов, а также некоторые лекарственные препараты. Врачи рекомендуют проводить комплексное обследование для выявления первопричины. Лечение зависит от основного заболевания: в некоторых случаях достаточно наблюдения и коррекции питания, в других — может потребоваться медикаментозная терапия. Важно, чтобы родители не игнорировали симптомы и обращались за медицинской помощью при первых признаках отклонений. Регулярные анализы крови помогут контролировать уровень нейтрофилов и предотвратить возможные осложнения.
https://youtube.com/watch?v=fqqCYW8R00U
Роль сегментоядерных нейтрофилов и норма у детей
Сегментоядерные нейтрофилы, попав из крови в органы, захватывают и поглощают болезнетворные организмы. Особенно эффективно их действие, направленное против бактерий и грибков. На вирусы они реагируют слабее. Нейтрализовав инфекционный агент, нейтрофил погибает. Но при этом выбрасывает в кровь порцию вещества, притягивающего к месту локализации инфекции другие клетки.
Кроме поглощения бактерий и грибов, сегментоядерные обладают еще одной способностью – очищать организм от засоряющих клеток.
Основной иммунный барьер у детей до 2-х лет создается сегментоядерными нейтрофилами. По мере взросления малыша меняется их содержание в крови.
- У новорожденных – 45-80 %,
- В 1 месяц – 16-45 %,
- В 1 год – 16-45 %,
- От 1 года до 6 лет – 25-60 %,
- От 6 до 12 лет – 35-65 %,
- От 12 до 15 лет – 45-65%.
Пониженный уровень сегментоядерных нейтрофилов в крови у ребенка
Нередко низкие нейтрофилы в крови у ребенка выявляют при низкой массе тела. Также нейтропения может быть результатом радиоактивного облучения, длительного пребывания на территории с плохой экологией. Некоторые лекарственные препараты (глюкокортикоидные гормоны, противосудорожные, болеутоляющие) вызывают понижение содержания сегментоядерных нейтрофилов в крови.
Если незадолго до сдачи крови ребенок перенес анафилактический шок, то количество нейтрофильных клеток в анализе тоже будет низким. К такому же результату приводят длительные стрессовые ситуации и физическое переутомление.
Наиболее опасными причинами уменьшения числа сегментоядерных клеток считаются онкологические заболевания, которые затрагивают внутренние органы и костный мозг. У детей, которые страдают почечной или печеночной недостаточностью, имеют проблемы с функционированием поджелудочной железы, часто наблюдается нейтропения.
Существует такое понятие, как «нейтропения невыясненного происхождения». В этом случае она носит врожденный характер или появляется в результате неустановленных причин. Это серьезная патология, которая становится причиной иммунодефицитного состояния.
Пониженные нейтрофилы у детей, или нейтропения, вызывают беспокойство у родителей и врачей. Многие родители отмечают, что это состояние может быть связано с различными инфекциями, наследственными факторами или даже реакцией на лекарства. Важно понимать, что нейтрофилы играют ключевую роль в иммунной системе, и их снижение может повышать риск инфекций.
Лечение отклонений зависит от причины. В некоторых случаях достаточно наблюдения и регулярного контроля анализов, в других — требуется медикаментозная терапия или изменение образа жизни. Родители часто делятся опытом, что правильное питание и укрепление иммунной системы могут помочь в восстановлении уровня нейтрофилов. Консультация с педиатром и, при необходимости, с гематологом поможет определить оптимальный подход к лечению и наблюдению за состоянием ребенка.
https://youtube.com/watch?v=scxUiiWtDRU
Что делать при понижении сегментоядерных нейтрофилов
Выявленную при сдаче общего анализа крови нейтропению у ребенка нельзя оставлять без внимания. Значительное (или длительное) снижение нейтрофилов имеет неприятные последствия. Снижается естественная иммунная защита малыша перед инфекциями. Особенно повышается восприимчивость к воздействию золотистого стафилококка и грамотрицательных бактерий.

Для поддержания иммунитета педиатры обычно прописывают ребенку витаминные комплексы. Специалисты рекомендуют следить за тем, чтобы ребенок полноценно питался, много времени проводил на свежем воздухе и не переутомлялся.
Тяжелая нейтропения требует наблюдения у гематолога. Нередко доктора прописывают препараты для повышения иммунитета. В некоторых случаях ребенку переливают кровь, назначают курс антибактериальной терапии.
Теперь вы знаете, как повысить нейтрофилы в крови у ребенка.
Доброкачественная и циклическая нейтропения
Существует особое состояние, при котором у ребенка в развернутом анализе крови обнаруживается сильное снижение количества сегментоядерных нейтрофилов. Специалисты называют его хронической доброкачественной нейтропенией.
Обнаруженное вскоре после рождения, такое состояние длится зачастую до двухлетнего возраста. Кроме показателей анализа, заболевание никак не проявляется. Малыш растет, развивается, не отставая от своих здоровых сверстников.
Заболевание не требует применения лекарств или особого режима. Единственное, что необходимо – наблюдение у гематолога.
Циклическая нейтропения обусловлена мутацией на уровне хромосом и передается по наследству рецессивными генами. Это заболевание встречается не часто. Для него характерно чередование периодов обострения и улучшения состояния ребенка.
Эта патология названа циклической из-за четких промежутков времени чередования фазы обострения и ремиссии. Чаще всего кризы длятся от 3 до 8 суток, периоды меду ними – от 2 недель до 3 месяцев.
Наряду с резким падением количества нейтрофилов, в момент обострения в анализе крови выявляют повышенное содержание моноцитов и эозинофилов. В различных частях тела ребенка появляются очаги, наполненные гноем. Как только криз заканчивается, показатели анализов приходят в норму, и малыш выздоравливает.
Чтобы облегчить состояние ребенка, за 2 недели до предполагаемой даты следующего обострения назначают медикаменты, стимулирующие развитие лейкоцитов. Такое лечение длится до нормализации показателя количества сегментоядерных нейтрофилов, отмеченной при лабораторном анализе.
Про отношение нейтрофилов и лимфоцитов можно прочитать здесь.
https://youtube.com/watch?v=WCgWRE10Xso
Вопрос-ответ
Что означает отклонение от нормы нейтрофилов?
Отклонения в количестве нейтрофилов могут свидетельствовать о различных состояниях организма. Например, при воспалительных процессах, инфекциях или травмах уровень нейтрофилов бывает повышен. Это состояние называется нейтрофилезом и связано с активностью иммунной системы в ответ на повреждение тканей.
Что нужно делать, чтобы повысить нейтрофилы?
Что нужно делать: каждый день принимайте тёплый душ, вытирайтесь досуха. Пользуйтесь увлажняющими кремами для кожи. Пользуйтесь только электрической бритвой. Соблюдайте гигиену полости рта, зубная щётка должна быть мягкой.
Что нельзя есть при пониженных нейтрофилах?
НЕЛЬЗЯ: недоваренные мясо, говядину, свинину, ягненка, рыбу, домашнюю птицу, мясо на кости, покупные салаты, продукты из охлажденной рыбы, сырое мясо, сырые или недоваренные яйца.
Советы
СОВЕТ №1
Обратите внимание на питание вашего ребенка. Убедитесь, что в его рационе присутствуют все необходимые витамины и минералы, особенно витамин C, цинк и железо, которые способствуют поддержанию иммунной системы и нормальному уровню нейтрофилов.
СОВЕТ №2
Регулярно проходите медицинские обследования. Это поможет своевременно выявить любые отклонения в анализах крови и другие проблемы со здоровьем, что особенно важно для детей с пониженными нейтрофилами.
СОВЕТ №3
Обратите внимание на общее состояние здоровья ребенка. Если вы заметили частые простуды, инфекции или другие симптомы, такие как усталость или слабость, обязательно проконсультируйтесь с врачом для дальнейшего обследования и возможного лечения.
СОВЕТ №4
Избегайте стрессовых ситуаций. Стресс может негативно влиять на иммунную систему ребенка. Постарайтесь создать для него спокойную и поддерживающую атмосферу, уделяйте время играм и отдыху на свежем воздухе.